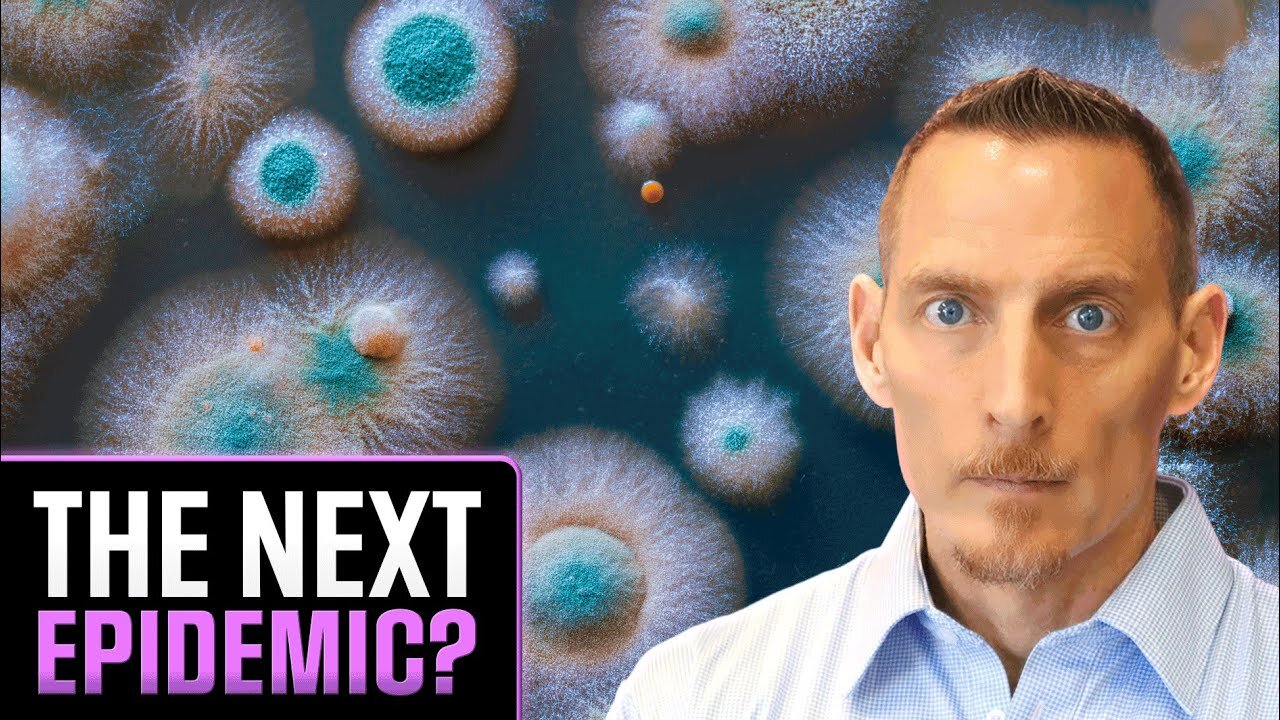

Premium Only Content
The Rising Mold Epidemic: Hidden Dangers of Mycotoxins & Mold-Related Illnesses
Want more info on Toxic Mold? https://moldjacked.com/
#MoldJacked #moldtoxicity
In this eye-opening presentation, Dr. Osborne discusses the growing concern of mold-related illnesses, warning that it could become a major epidemic in the U.S. He explains how symptoms go beyond typical mold allergies, touching on mycotoxicosis, skin rashes, and unexplained fevers. Sharing personal stories from his own experience with mold exposure, Dr. Osborne addresses the challenges of diagnosing these issues, often mistaken for other conditions like viruses or childhood illnesses.
He also critiques the limitations of traditional mold testing and emphasizes the need for greater awareness of the dangers posed by mycotoxins, which can contribute to severe health problems like autoimmune diseases and cancer.
Dr. Osborne advocates for a holistic recovery approach, including dietary changes and psychological support, and urges viewers to educate others on the risks of mold exposure to help prevent a health crisis in the future.
Join us on Tuesday night at 6:00 PM! For more info, visit moldjacked.com
Gluten Sensitive? Take the quiz & Join Our Community ▶
https://www.glutenfreesociety.org/gluten-sensitivity-intolerance-self-test/
Get my quick start guide on going gluten free: https://www.glutenfreesociety.org/how-to-go-gluten-free/
Nutritional Crash Courses Playlist: https://www.glutenfreesociety.org/nutrition
Get Gluten Free Supplements: https://www.glutenfreesociety.org/shop-home/
No Grain No Pain the Book: https://www.glutenfreesociety.org/NoGrainNoPain
Glutenology Masterclass (Ultimate Guide): https://glutenology.net/registration
To connect with Dr. Osborne visit:
On the web: https://drpeterosborne.com/
Facebook: https://www.facebook.com/DoctorPeterOsborne/
TikTok: https://www.tiktok.com/@drpeterosborne
Instagram: https://www.instagram.com/drosborne
Twitter: https://twitter.com/glutenology
Pinterest: https://www.pinterest.com/docosborne/
Podcast:
Apple Podcasts: https://podcasts.apple.com/us/podcast/dr-osbornes-zone/id1706389688?uo=4
Spotify: https://open.spotify.com/show/4Zdf07GgpRAVwlSsYvirXT
Amazon Music/Audible: https://music.amazon.com/podcasts/20d71b2e-3554-4569-9d5b-4259785cdc94
Google Podcasts: https://www.google.com/podcasts?feed=aHR0cHM6Ly93d3cuc3ByZWFrZXIuY29tL3Nob3cvNTkwNjcwNC9lcGlzb2Rlcy9mZWVk
iHeart Radio: https://iheart.com/podcast/119388846
Dr. Peter Osborne is one of the most sought after alternative and nutritional experts in the world. A Diplomate with the American Clinical Board of Nutrition, a graduate of Texas Chiropractic College, and a doctor of pastoral science, Dr. Osborne is one of the world’s leading authorities on gluten, nutrition, and natural health. He is the founder GlutenFreeSociety.org, one of the world's largest informational sites on gluten sensitivity. In addition, he is the author of the best selling book, No Grain No Pain, published by Touchstone (Simon & Schuster). His work has been featured by PBS, Netflix, Amazon, Fox, U.S. News, Ney York Post, and many other nationally recognized outlets.
For collaborations please email: glutenology@gmail.com
Any information on diseases, treatments, nutrition, or other health related topics from this channel are for educational purposes only, and should not be considered a substitute for advice provided by your doctor or healthcare provider. Bottom line...if you have health issues, you should always seek professional medical guidance.
Products and supplements discussed in this video have not been evaluated by the FDA. They are not intended to treat, cure, or diagnose.
Dr. Osborne is an Amazon affiliate, and many earn from qualifying purchases.
For more information, visit us at https://www.glutenfreesociety.org/
or call 281-903-7527
-
 LIVE
LIVE
Laura Loomer
2 hours agoEP118: LIVE COVERAGE: Trump Celebrates 100 Days In Office At Michigan Rally
2,106 watching -
 LIVE
LIVE
Barry Cunningham
8 hours agoWATCH TRUMP RALLY LIVE: PRESIDENT TRUMP MARKS 100 DAYS IN OFFICE WITH A RALLY IN MICHIGAN
1,538 watching -
 LIVE
LIVE
Badlands Media
8 hours agoBadlands Media Special Coverage: President Trump's 1st 100 Days Rally
1,440 watching -
 LIVE
LIVE
Sarah Westall
1 hour agoA Globalist Agenda or Chinese Payback? Fentanyl #1 Cause of Death for People Under 49
126 watching -
 LIVE
LIVE
LFA TV
22 hours ago| TRUMPET DAILY 4.29.25 7PM
145 watching -
 16:12
16:12
T-SPLY
8 hours agoJeff Bezos Is Now Enemy #1 For The Trump Administration
32.3K37 -
 7:27
7:27
China Uncensored
7 hours agoChina’s DISTURBING Expansion in Africa
7503 -
 1:24:27
1:24:27
Redacted News
3 hours agoELECTION SHOCK! Canada Declares War on U.S. and Trump, India going to war with Pakistan? | Redacted
109K209 -
 1:18:53
1:18:53
vivafrei
6 hours agoCanada Elected a Globalist, WEF, 3-Passport-Carrying Manchurian Candidate! And Other News! Viva Frei
67K80 -
 1:30:14
1:30:14
Michael Franzese
4 hours agoFace to Face with a Former Mexican Mafia Hitman
30K2